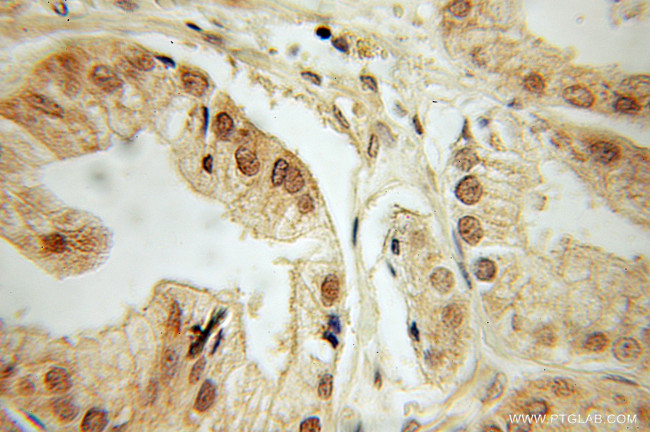
DEDD Antibody in Immunohistochemistry (Paraffin) (IHC (P))

Search
Proteintech
DEDD Polyclonal Antibody
{{$productOrderCtrl.translations['antibody.pdp.commerceCard.promotion.promotions']}}
{{$productOrderCtrl.translations['antibody.pdp.commerceCard.promotion.viewpromo']}}
{{$productOrderCtrl.translations['antibody.pdp.commerceCard.promotion.promocode']}}: {{promo.promoCode}} {{promo.promoTitle}} {{promo.promoDescription}}. {{$productOrderCtrl.translations['antibody.pdp.commerceCard.promotion.learnmore']}}
产品信息
10816-1-AP
种属反应
已发表种属
宿主/亚型
分类
类型
抗原
偶联物
形式
浓度
规格
纯化类型
保存液
内含物
保存条件
运输条件
产品详细信息
Immunogen sequence: MAGLKRRAS QVWPEEHGEQ EHGLYSLHRM FDIVGTHLTH RDVRVLSFLF VDVIDDHERG LIRNGRDFLL ALERQGRCDE SNFRQVLQLL RIITRHDLLP YVTLKRRRAV CPDLVDKYLE ETSIRYVTPR ALSDPEPRPP QPSKTVPPHY PVVCCPTSGP QMCSKRPARG RATLGSQRKR RKSVTPDPKE KQTCDIRLRV RAEYCQHETA LQGNVFSNKQ DPLERQFERF NQANTILKSR DLGSIICDIK FSELTYLDAF WRDYINGSLL EALKGVFITD SLKQAVGHEA IKLLVNVDEE DYELGRQKLL RNLMLQALP (1-318 aa encoded by BC013910 )
靶标信息
DEDD encodes a protein that contains a death effector domain (DED). DED is a protein-protein interaction domain shared by adaptors, regulators and executors of the programmed cell death pathway. Overexpression of this gene was shown to induce weak apoptosis. Upon stimulation, this protein was found to translocate from cytoplasm to nucleus and colocalize with UBTF, a basal factor required for RNA polymerase I transcription, in the nucleolus. At least three transcript variants encoding the same protein have been found for this gene.
仅用于科研。不用于诊断过程。未经明确授权不得转售。
生物信息学
蛋白别名: contains DED-like domain; Death effector domain-containing protein; Death effector domain-containing testicular molecule; DEDD; DEDPro1; FLDED-1; unnamed protein product
基因别名: CASP8IP1; DEDD; DEDD1; DEDPRO1; DEFT; FLDED-1; FLDED1; KE05
UniProt ID: (Human) O75618
Entrez Gene ID: (Human) 9191